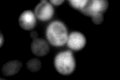
YFL014W
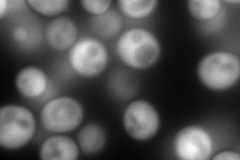
YFL014W
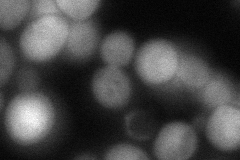
YFL014W
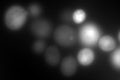
YFL014W

View description
Plasma membrane localized protein that protects membranes from desiccation; induced by heat shock, oxidative stress, osmostress, stationary phase entry, glucose depletion, oleate and alcohol; regulated by the HOG and Ras-Pka pathways
Localization:
Intensity:
Fold change:
Significance:
-
C’ GFP library in SD
cytosol310.57 -
N' NOP1pr-GFP in SD
cytosol316.202 -
N' TEF2pr-mCherry in SD

vacuole599.256 -
N' NATIVEpr-GFP in SD

cytosol372.882 -
N' TEF2pr-VC and Cyto-VN in SD
cytosol91.0606 -
C’ GFP library in SD+DTT
cytosol608.661.95Yes -
C’ GFP library in SD+H2O2

cytosol770.222.47Yes -
C’ GFP library in Starvation Media

cytosol2532.768.15Yes -
C’ GFP library on the background of Pup2-DaMP

cytosol -
C’ GFP library on the background of CCT mutant

cytosol193.9580.624507Yes
